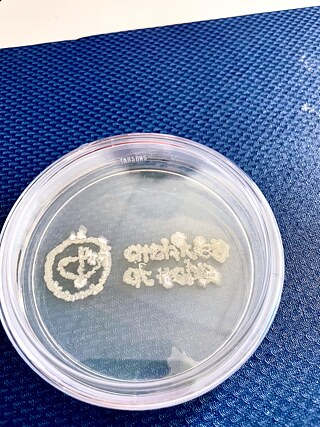
Logo from the bacterial cultures © © Line Krom Logo from the bacterial cultures collected in the archives_Line Krom

Line Krom
bangaloREsident@NCBS
Line Krom ist bildende Künstlerin und lebt in Frankfurt/M. Ihr Hintergrund als Kulturanthropologin lässt sie auf die Umstände blicken unter denen Kunst entsteht. Mit künstlerischen Methoden erforscht sie prekäre Arbeitsbedingungen im Kunstbetrieb. Die Ergebnisse ihrer Projekte manifestieren sich in Zeichnungen, Objekten, Installationen, Texten, Performances und partizipatorischen Situationen.
Im Rahmen der bangaloREsidency untersucht sie am National Centre for Biological Sciences (NCBS) die In- bzw. Exkludierungsstrategien des Archivs. Was gehört in das Archiv des NCBS und was nicht? Wer darf Wissenschaftsgeschichte schreiben und wer nicht? Die bangaloREsidency ermöglich Krom eine kritische, ästhetische Auseinandersetzung mit dem Archiv des NCBS, seinen überschüssigen Materialien und Abfällen, wie beispielsweise dem Archiv Staub. Staub ist ein Material das im Archiv entsteht und das regelmässig entfernt wird.
Mit Staub aus Museen arbeitet Krom bereits seit einigen Jahren. In ihrer Ausstellung "Cleaning and other tasks done for pleasure" im Kunstverein Nachtspeicher 23 in Hamburg (2019) präsentierte sie eine Staubmalerei, gefertigt aus dem Staub, Kaffeesatz und Sägemehl verschiedener Kunstvereine in Europa. U.a. aus der Ausstellungshalle Port 25, Mannheim, dem Projektraum |Meter|, Kopenhagen und der Konsthall C, Stockholm, die ihre Abfälle spendeten.
Für Krom symbolisiert Staub ein schöpferisches Element, da er sich ohne weiteres Zutun vermehrt - eine Metapher für ökonomische Beschwörungsversuche und Wertschöpfungszwänge. Das NCBS und sein Archiv bilden den Rahmen für die Weiterentwicklung von Kroms Phyto-Mining Arbeit „Dust2Gold“ in der die Künstlerin mittels Pflanzen als nicht-menschlichen Kollaborateuren plant, aus Staub und Abfällen wertvolle Metalle zu schürfen.
Gegenwärtig unterrichtet Krom an der Hochschule für Gestaltung Offenbach und am Institut für Kunstpädagogik der Goethe Universität Frankfurt. Seit 2014 unterrichten sie regelmässig an Hochschulen. Line Krom studierte an der Goethe Universität Frankfurt, der UdK Berlin und der UAL London.
Gezeigt wurde Kroms Arbeiten u. a. im Jerwood Space London, der Blyth Gallery London und dem BronxArtSpace New York, L.A. Book Fair Los Angeles. Zuletzt war sie mit Einzelausstellungen „Hortus Pecuniae - Garten des Geldes“ im Kunstturm Mücke (2022), „Numbers Rule - Zahlen im Blick“ im Frauen Museum Wiesbaden (2020) und „Trim the Fat!“ im Neuen Kunstverein Gießen (2020) präsent.
Im Rahmen der bangaloREsidency untersucht sie am National Centre for Biological Sciences (NCBS) die In- bzw. Exkludierungsstrategien des Archivs. Was gehört in das Archiv des NCBS und was nicht? Wer darf Wissenschaftsgeschichte schreiben und wer nicht? Die bangaloREsidency ermöglich Krom eine kritische, ästhetische Auseinandersetzung mit dem Archiv des NCBS, seinen überschüssigen Materialien und Abfällen, wie beispielsweise dem Archiv Staub. Staub ist ein Material das im Archiv entsteht und das regelmässig entfernt wird.
Mit Staub aus Museen arbeitet Krom bereits seit einigen Jahren. In ihrer Ausstellung "Cleaning and other tasks done for pleasure" im Kunstverein Nachtspeicher 23 in Hamburg (2019) präsentierte sie eine Staubmalerei, gefertigt aus dem Staub, Kaffeesatz und Sägemehl verschiedener Kunstvereine in Europa. U.a. aus der Ausstellungshalle Port 25, Mannheim, dem Projektraum |Meter|, Kopenhagen und der Konsthall C, Stockholm, die ihre Abfälle spendeten.
Für Krom symbolisiert Staub ein schöpferisches Element, da er sich ohne weiteres Zutun vermehrt - eine Metapher für ökonomische Beschwörungsversuche und Wertschöpfungszwänge. Das NCBS und sein Archiv bilden den Rahmen für die Weiterentwicklung von Kroms Phyto-Mining Arbeit „Dust2Gold“ in der die Künstlerin mittels Pflanzen als nicht-menschlichen Kollaborateuren plant, aus Staub und Abfällen wertvolle Metalle zu schürfen.
Gegenwärtig unterrichtet Krom an der Hochschule für Gestaltung Offenbach und am Institut für Kunstpädagogik der Goethe Universität Frankfurt. Seit 2014 unterrichten sie regelmässig an Hochschulen. Line Krom studierte an der Goethe Universität Frankfurt, der UdK Berlin und der UAL London.
Gezeigt wurde Kroms Arbeiten u. a. im Jerwood Space London, der Blyth Gallery London und dem BronxArtSpace New York, L.A. Book Fair Los Angeles. Zuletzt war sie mit Einzelausstellungen „Hortus Pecuniae - Garten des Geldes“ im Kunstturm Mücke (2022), „Numbers Rule - Zahlen im Blick“ im Frauen Museum Wiesbaden (2020) und „Trim the Fat!“ im Neuen Kunstverein Gießen (2020) präsent.